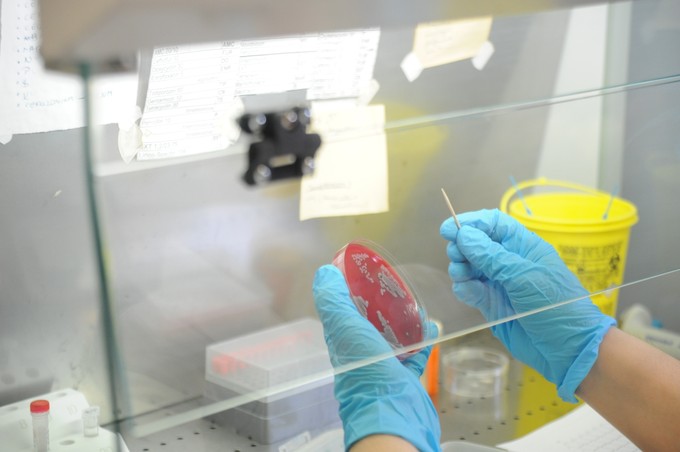
Ez lesz a vezető halálok a jövőben című cikk nyitóképe

Orvosi gyógymódok

Tesztelje tudását a gyógynövényekről!
Mennyire ismeri ki magát a gyógynövények világában?

Gyógynövények pikkelysömörre: Szabó Gyuri bácsi tanácsai
Létezik egy gyógynövény, amely a legtöbb bőrbetegségnél hasznos gyógyír lehet. Nem, most nem a körömvirágról lesz szó - hanem az ekcémára és pikkelysömörre is hatékony vadárvácskáról!

Ennyien halhatnak meg a jövőben évente antibiotikum-rezisztencia miatt
A Covid-19 nem az első és nem is az utolsó egészségügyi kihívás, amivel globális szinten meg kell majd küzdeni – derül ki a Roland Berger megatrendekről szóló elemzéséből.

Antibiotikumok mellékhatásai: a génszerkesztett baktériumok segíthetnek?
Kutatók génszerkesztéssel olyan baktériumtörzset hoztak létre, ami antibiotikumok szedése mellett megvédheti a bélflórát.

Büdös mosogatószivacs - ez okozza a szagot
Nincsen annál gyomorforgatóbb, amikor az ember orrát megcsapja a mosogatószivacs szaga. Ez az oka a gyors büdösödésnek!

Formás, szálkás lábak és kerek popsi: ezeket a gyakorlatokat végezze
Nálunk, nőknél jellemzően a comb és fenék a kritikus pont, súlyfeleslegnél is itt kerekedünk a legkönnyebben. Ha a túlsúly már jó ideje fennáll, akkor a fogyás ízületvédelem szempontjából is fontos, nem csak esztétikai kérdés!

31 innovatív gyógyszeres terápia támogatása ad új esélyt a magyar betegeknek
Többezer magyar betegnek javulhatnak az életkilátásai, miután mintegy kétéves kihagyást követően újra döntés született új terápiák társadalombiztosítási támogatásba való befogadásról.

Természetes elsősegélydoboz: így is elbánhat a munkahelyi sérülésekkel
Dr. Sebő Zsuzsanna mentőorvos 4+1 munkahelyi sérülésekhez ad különleges, természetes megoldásokra koncentráló tanácsot.